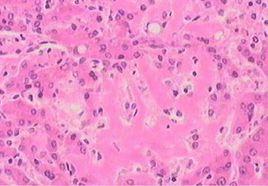
肝臟澱粉樣物質沉積症 肝臟澱粉樣物質沉積症

疾病名稱
肝臟澱粉樣物質沉積症
英文名稱
肝臟澱粉樣變;肝臟澱粉樣變性;肝臟澱粉樣變性病;肝澱粉樣變性
分類
消化科 > 肝膽疾病 > 肝臟先天性及代謝性疾病
病因
澱粉樣變性性病因及發病機制尚不清楚,一般認為主要是由於各種原因導致的澱粉樣變性物質浸潤於細胞之間,或沉積於小血管基底膜下,或沿網狀纖維支架沉積。
發病機制
當病變進行時,這些沉積物質壓迫和破壞這些組織而導致器官衰竭和死亡。將澱粉樣變性纖維分離純化作胺基酸序列分析發現澱粉樣纖維有3種蛋白類型:
AL型蛋白
AL型蛋白來源於免疫球蛋白的輕鏈(特別是可變區),N-端序列和免疫球蛋白輕鏈的部分區域同源,包括κ型及λ型,λ型輕鏈比κ型更易形成澱粉樣纖維,見於原發性澱粉樣變性及多發性骨髓瘤伴發的澱粉樣物質沉積症。
AA型蛋白
AA型蛋白與稱為AA蛋白的非免疫性球蛋白有相同的N-末端序列,澱粉樣纖維似與輕鏈無關,主要的澱粉樣纖維由一種不同於免疫球蛋白的A蛋白組成,可能是由於漿細胞產生的免疫球蛋白經吞噬細胞溶酶體酶的蛋白水解作用轉變而成,見於繼發性及家族性地中海熱伴發的澱粉樣物質沉積症。
AF型蛋白
澱粉樣纖維主要為正常或異常的前白蛋白複合物(分子量14000),通常為轉甲狀腺素蛋白(前清蛋白)的單個胺基酸置換產物,其次為 β2微球蛋白,主要見於家族性澱粉樣物質沉積症。
臨床上根據澱粉樣變性累及器官情況可分為全身性和局限性。根據原疾病的有無可分為原發性、繼發性或遺傳性(表1)。
肝臟澱粉樣物質沉積症的臨床表現
澱粉樣變性臨床上無特異性症狀和體徵,其症狀決定於原有疾病及澱粉樣物質沉積的部位、沉積量以及所受累的器官和系統,症狀常被原發疾病所掩蓋。
繼發性、全身性澱粉樣變性95%以上有肝臟受累,常表現為肝大、上腹脹滿、納差,少數可表現為嚴重肝大(肝重量可達7kg以上)。但肝功能損害均較輕微,偶有門靜脈高壓而表現為食管、胃底靜脈曲張和腹水等,極少數可有黃疸。
肝臟澱粉樣物質沉積症的併發症
有繼發性感染、心腎功能衰竭和肝硬化腹腹水等。
實驗室檢查
肝功能(谷丙轉氨酶、穀草轉氨酶)、出凝血時間大多正常,或輕度異常改變,大多表現為γ谷氨醯轉肽酶及鹼性磷酸酶上升。膽紅素超過85.5μmol/L罕見。可出現貧血、蛋白尿等。血沉可正常或增快。
輔助檢查
影像學檢查 缺乏特異性,超聲檢查主要改變為:肝臟體積增大,肝實質呈粗大點狀均勻回聲,門靜脈可增寬,有時可見腹水形成。CT主要表現為:肝大,肝臟瀰漫性低密度區,增強不明顯,肝內血管不移位。
診斷
根據症狀、體徵及輔助檢查可對澱粉樣變性做出初步診斷,確診需靠組織活檢,皮膚和直腸黏膜活檢是最常用的篩查方法,其他活檢部位有齒齦、神經、腎和肝臟等。對於疑診原發性肝臟澱粉樣物質沉積症者,可直接行肝臟活檢。對於肝臟明顯腫大的澱粉樣變性患者由於肝被膜緊張,肝穿刺有引發肝破裂或肝出血的危險,臨床應慎重。對於全身性澱粉樣變性患者胃、直腸黏膜活檢大多安全有效。
鑑別診斷
肝臟澱粉樣變性需與引起肝腫大的各種肝臟疾病做鑑別診斷,如急性肝炎、各種原因所致肝硬化、原發或繼發性肝癌、肝豆狀核變性等。
肝臟澱粉樣物質沉積症的治療
目前尚無特異療法。其治療目的是防止澱粉樣物質的進一步沉積,促進或加速已沉積的澱粉樣物質的吸收。
原發性澱粉樣變性治療
常用治療方案是美法侖(苯丙氨酸氮氮氮芥) 潑尼松(MP)方案。由於烴化劑對非免疫球蛋白型澱粉樣變性無效,因此在開始治療前必須確定原發性澱粉樣變性的診斷。有人比較了MP方案與秋水仙鹼對照治療結果,MP方案長期治療能使肝臟澱粉樣物質沉積症完全消退,腫大的肝臟恢復正常,質地變軟,升高的血清鹼性磷酸酶水平顯著下降,存活期較秋水仙鹼明顯延長。MP方案的用法:美法侖0.15mg/(kg·d),分2次口服;潑尼松0.8mg/(kg·d),分4次口服,1周為1療程,每6周重複一個療程,可長達數月至數年;美法侖每個療程增加2mg/d,直至出現中等程度的白細胞或血小板減少,如發生嚴重的白細胞或血小板減少,美法侖的劑量亦要相應減少。值得注意的是MP方案治療期間可並發嚴重的病毒感染。
繼發性澱粉樣變性治療
(1)控制基礎疾病:如慢性骨髓炎、結核病、類風濕性關節炎等。基本病因的控制較好,澱粉樣變性可停止發展甚至消退。
(2)二甲亞碸(DMSO):原為一種工業用溶劑,後發現其有以下作用:
①在體外能溶解澱粉樣纖絲並增加其對降解酶的敏感性。
②抑制血清澱粉樣蛋白A合成,減少AA蛋白在組織中的沉積。
③抑制炎症反應。
二甲亞碸對原發性澱粉樣變性無效,對繼發性澱粉樣變性患者能使腎功能改善,腫大的肝臟恢復正常,澱粉樣物質輕度減少,生存期也有改善。其用法為每15g配成10%溶液分3次在餐前與果汁同服,至少套用6個月。若無效時改用其他方法;有效者繼續套用,病情控制後逐漸減量,並以合適劑量維持,療程可長達數年。減量過早、過快或驟然停藥均可導致病情惡化。二甲亞碸無毒性,長期套用安全。不良反應:僅有輕度噁心,但呼出氣味難聞,許多患者因此而中止治療。
(3)對症治療:如有效治療心力衰竭和腎功能衰竭。慎用洋地黃。可考慮腎移植。
預後
肝臟澱粉樣物質沉積症預後較差,自然病程1~5年,原發性澱粉樣變性患者的平均生存期為2年。生存期的長短取決於伴發何種併發症,晚期多死於心功能不全或多臟器功能衰竭。
肝臟澱粉樣物質沉積症的預防
1.積極治療原發病 對於繼發性澱粉樣變性患者,如能控制類風濕關節炎、慢性骨髓炎、結核病及多發性骨髓瘤等原發病,肝臟澱粉樣物質沉積症可能消退。
2.積極鍛鍊身體 增強機體的免疫能力,對預防本病的發生有一定幫助。此外還應囑患者調達情志,保持心情舒暢。
3.肝臟澱粉樣物質沉積症患者的死亡原因為繼發性感染和心腎功能衰竭。因此,需密切觀察病情變化,一旦發生上述情況,應立即搶救,以減少病死率。
相關藥品
剛果紅、美法侖、苯丙氨酸氮芥、氮芥、潑尼松、秋水仙鹼、洋地黃
相關檢查
免疫球蛋白輕鏈、漿細胞、凝血時間、丙氨酸、血清鹼性磷酸酶、血清澱粉樣蛋白A